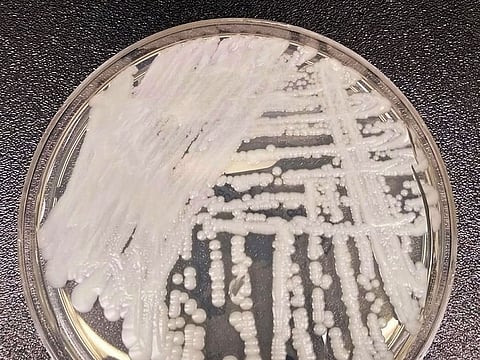
A strain of Candida auris cultured in a petri dish at a CDC laboratory.

CDC says the highly drug-resistant fungus 'presents a serious global health threat'
A deadly fungal infection is spreading at "an alarming rate" inside health facilities and long-term-care hospitals across the United States, the Centers for Disease Control and Prevention said Monday.
Here's what to know about the highly drug-resistant fungus - a strain of a kind of yeast known as Candida auris (or C. auris for short) that the CDC says "presents a serious global health threat."
While healthy people are not likely to contract the infection, those with lower immunity and people living in nursing homes are more likely to fall sick and be unable to fight the infection, and the outcome can be fatal.
Candida is a family of yeasts that can be found on the skin and inside the body. Usually, the fungus lives in areas such as the mouth, throat, gut and vagina, without causing health problems. Common types of Candida include "Candida albicans," which causes the yeast infection thrush.
Sometimes, however, certain types of Candida can cause infection in older people and those battling other health issues.
C. auris was first discovered in the ear canal of a patient in Tokyo in 2009. It can enter the body during medical treatment, including operations or when urinary catheters, tubes or drips are inserted. It can also infect surgical wounds.
While the number of cases recorded by the CDC is only in the thousands, it is considered a serious global public health threat because it is drug resistant and has the potential to spread among the most medically vulnerable. It is also difficult to identify using standard laboratory methods, and it has caused outbreaks in health-care environments across the country.
Candida auris can enter the bloodstream and spread throughout the body, causing invasive infections. Fever and chills that don't improve after antibiotic treatment for suspected bacterial infections are the most common symptoms of invasive candidiasis, the CDC notes.
The infection can aggravate various parts of the body, including the ears, heart, kidneys, eyes and brain.
The infection spreads easily from person to person - especially within hospital environments and among the medically vulnerable. It can also be spread through contact with infected surfaces and lingers on objects including hospital equipment such as bed rails, chairs and windowsills.
The infection can also be resistant to certain cleaning products, making it harder for the fungus to be eradicated from hospital wards.
People can also carry the infection without experiencing symptoms, unknowingly spreading the infection to other people who may be more at risk, such as people in long-term health-care facilities, including nursing home patients on ventilators, those with diabetes and cancer patients.
Those who take lots of antibiotics or antifungal medications appear to be at highest risk of infection, according to the CDC.
Between 30 percent and 60 percent of hospitalized people who develop bloodstream infections are estimated to die, according to CDC data. However, the CDC notes that many of these patients had other serious illnesses that increased their risk of death.
The CDC says more work is needed to understand how the infection spreads.
C. auris was diagnosed in a handful of patients in the United States in 2016, where clinicians on American soil had been warned by health officials to be on the lookout for the infection.
It has since been detected in more than 20 states, with the most cases recorded in Nevada, California, Florida New York, Illinois and Texas in the past 12 months, according to case counts provided to the CDC by local and state health departments.
Fungal infections from Candida auris tripled nationally from 476 in 2019 to 1,471 in 2021, the CDC said Monday.
Since it was first reported in Asia in 2009, the fungus has been reported in a slew of countries, including Colombia, India, Israel, Kenya, Kuwait, Pakistan, South Korea, Venezuela and Britain.
Transmission of the infection was facilitated by international travel, according to the CDC, though experts say that climate change may also be fueling the infection. The infection also worsened amid the coronavirus pandemic, which hospitalized more people around the world, overburdening health-care staff who were forced to reuse personal protective equipment.
Clinical cases of C. auris soared about 60 percent in 2020 compared to 2019, according to a 2022 report from the CDC that noted the global pandemic "likely intensified spread of C. auris and hindered detection of additional cases."
One leading theory suggests that Candida has evolved to survive in a warming world, while other theories suggest that widespread use of antifungal drugs along with heavy use of fungicide on crops may have sparked the emergence of the fungus.
The CDC says that several infection control measures can help prevent C. auris, including adherence to hand hygiene and thoroughly cleaning hospital environments. Equipment that is shared among patients, such as blood pressure cuffs, temperature probes and ultrasound machines, should be thoroughly disinfected frequently.
Alcohol-based hand sanitizer, gowns and gloves should also be used to reduce the spread of infection inside health-care facilities.
According to the CDC, those who have the infection and their close contacts do not have to self-isolate and can participate in social activities as long as they maintain good hand hygiene.
The infection is difficult to identify with standard laboratory methods because the yeast can be mistaken for other organisms, so specific technology is needed, the CDC says.
While the CDC says most C. auris infections are treatable with antifungal medications called echinocandins, some strains of the infection have developed a resistance to antifungal drugs, making it harder to treat patients, and cases of reinfection have also been recorded.